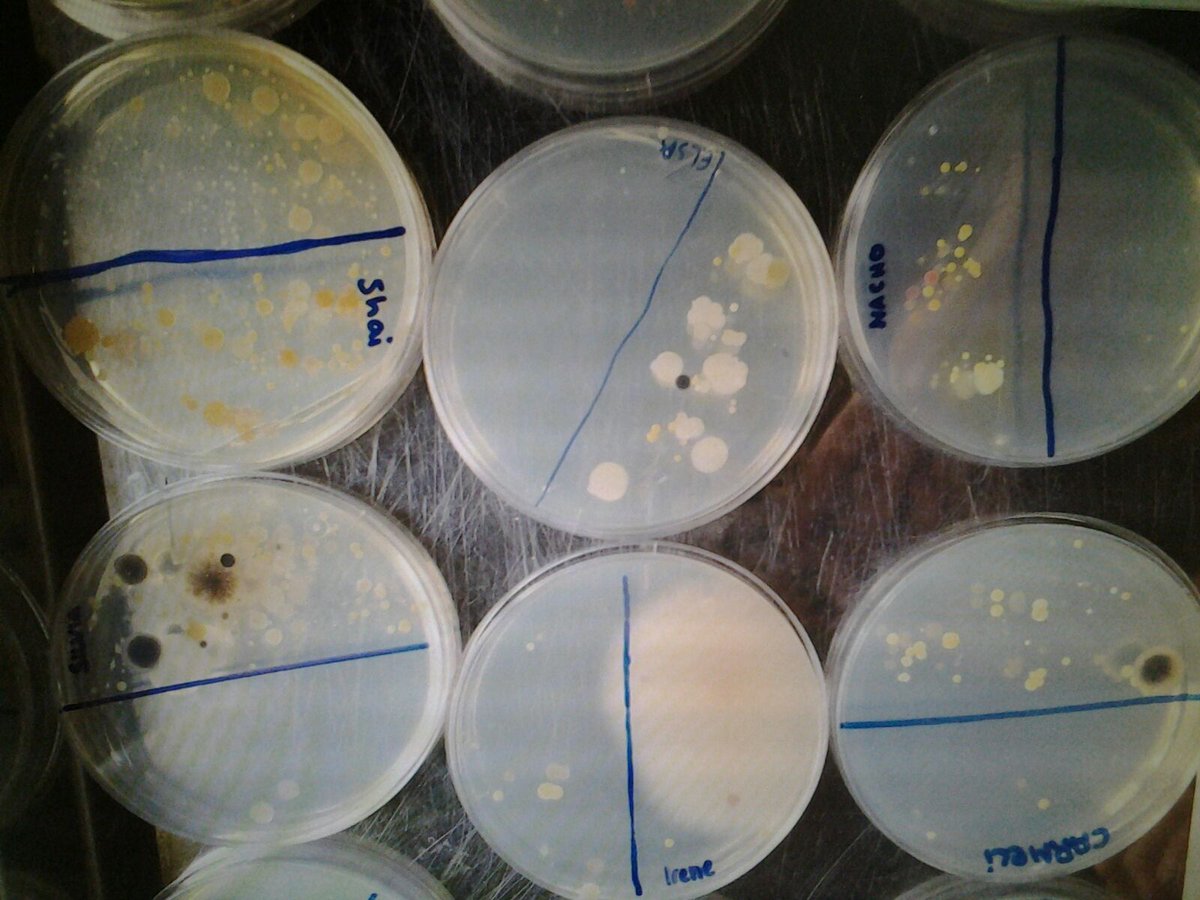
ASBASbiotec's tweet image. Un poco de ciencia  microbiana en el Biotechnofarm, con los alumnos del Instituto de la Ería. Qué la Biotecnología se extienda cual virus ;3

You might like
El 19 de mayo comienza el Foro Crecer Innovando CREAMA 2021 en el que participaré como ponente 💚 Hablaremos sobre turismo digital. Si eres profesional o te interesa el sector turístico, ¡inscríbete! 🤗 @creama_org @focuspyme @ceeielche @GVAivace @emprenemjunts @CValencianaTB
🛎️🛎️🛎️ Foro Crecer Innovando @creama_org 2021 4⃣ sesiones sobre el #turismo que viene y cómo adaptarse. Online 📅19 y 26 mayo; 2 y 9 junio Con Antonia Ferrer, @JonHormaetxe, @clara_soler y @_Zeny_3 ¡Inscríbete! @GVAivace @ceeielche @emprenemjunts bit.ly/3u82gbg
Los babuinos gelada son una especie de primate terrestre, que pasa el tiempo alimentándose en las praderas, de los arbustos, hierbas y raíces que hay sobre el suelo. 🔽🔽🔽🔽

Plásticos en las Fosa de las Marianas, a casi 11 km de profundidad

El Canto del Indri, una experiencia única e inolvidable | #fauna #África #Madagascar #viajes| travelmesoftly.com/canto-del-indr…
Can anyone ID these eggs NE US found in a flower pot, pretty sure its two different species. goo.gl/KxWys1
“Transgénicos sin miedo” en Hoy por Hoy. jmmulet.naukas.com/2017/06/23/tra… vía @jmmulet
jmmulet.naukas.com
«Transgénicos sin miedo» en Hoy por Hoy. - Tomates con genes
Nadie dijo que hablar de transgénicos sea fácil. La semana pasada estuve en Hoy por Hoy, el programa que presenta Gemma Nierga (junto a Pepa Bueno), hablando de transgénicos con Javier Gregori y Toño...
Planifica tu viaje independiente! con @travelmesoftly ht.ly/5UyS30c6hjN
¿Conoces el barranco de Mela? Un lugar precioso que disfrutamos con #Akraventuras, ¡no te lo pierdas! #Alicante travelmesoftly.com/barranquismo-a…

El desierto de Thar (India) visto desde el espacio. ¡Sorprendente!, ¿verdad?: muyinteresante.es/ciencia/fotos/…

Allá donde voy me gusta mimetizarme. Para #VacacionesBlogger2 tocaba estudiar estilismo y patois jamaiquino @bthetravelbrand @mochilerostv
2/4.Una vez estudiadas las bases del patois jamaicano...a planificar las #VacacionesBlogger2 #laplanificadora @bthetravelbrand @mochilerostv

Un poco de ciencia microbiana en el Biotechnofarm, con los alumnos del Instituto de la Ería. Qué la Biotecnología se extienda cual virus ;3
La vacunación es esencial, tanto en casa como cuando se viaja al extranjero. #vacunas #graciasciencia
La recopilación más clara y completa sobre las vacunas para viajar a Asia travelmesoftly.com/vacunas-para-v… #Asia #viajar #viajeros #saludviajera
Fiebre amarilla, ¿qué es y cómo prevenirla? travelmesoftly.com/fiebre-amarill… #saludviajera #ViajarEsVivir
Desde ASEBIO os deseamos que paséis unas fiestas estupendas y que te tengáis muchos éxitos en 2017 ¡y mucha biotecnología!

United States Trends
- 1. Happy New Year 3,57 Mn posts
- 2. Happy 2026 3,02 Mn posts
- 3. Chelsea 260 B posts
- 4. Maresca 237 B posts
- 5. AI Alert 3.118 posts
- 6. Market Focus 2.386 posts
- 7. Welcome to 2026 127 B posts
- 8. Jack Smith 239 B posts
- 9. Token Signal 1.928 posts
- 10. #ThankYouCampingWorld 3.454 posts
- 11. Good Thursday 8.931 posts
- 12. Mother of God 8.744 posts
- 13. Quran 96,1 B posts
- 14. Solemnity of Mary 3.558 posts
- 15. #ThursdayThoughts N/A
- 16. Runaway 5.746 posts
- 17. AI Alpha 6.161 posts
- 18. #RoseBowl 1.945 posts
- 19. Crans-Montana 28,8 B posts
- 20. #thursdayvibes N/A
You might like
-
 Desgranando Ciencia / Hablando de Ciencia
Desgranando Ciencia / Hablando de Ciencia
@Sci_Granada -
 José Ramón Alonso
José Ramón Alonso
@jralonso3 -
 Tercer Milenio
Tercer Milenio
@milenioheraldo -
 Conversus IPN
Conversus IPN
@Conversus_IPN -
 SEBBM
SEBBM
@SEBBM_es -
 Apadrina la Ciencia
Apadrina la Ciencia
@ApadrinaCiencia -
 Olimpiada Biología
Olimpiada Biología
@olimpiadabio -
 Gomez Cano AR
Gomez Cano AR
@argcPALEO -
 Ciencia, no Ficción
Ciencia, no Ficción
@CiencianoFiccio -
 Jennifer Miranda
Jennifer Miranda
@JMirandaPSOE -
 Luis Fontana
Luis Fontana
@fontanagallego -
 Sergio Álvarez
Sergio Álvarez
@sergio203bio -
 minasenergiaupm
minasenergiaupm
@minasenergiaupm -
 Sociedad CERFA
Sociedad CERFA
@SociedadCerfa -
 Patricia (Pat) Castillo-Briceno 👩🏽🔬🌊❄🌐💜
Patricia (Pat) Castillo-Briceno 👩🏽🔬🌊❄🌐💜
@Pcasbri
Something went wrong.
Something went wrong.
































































































































